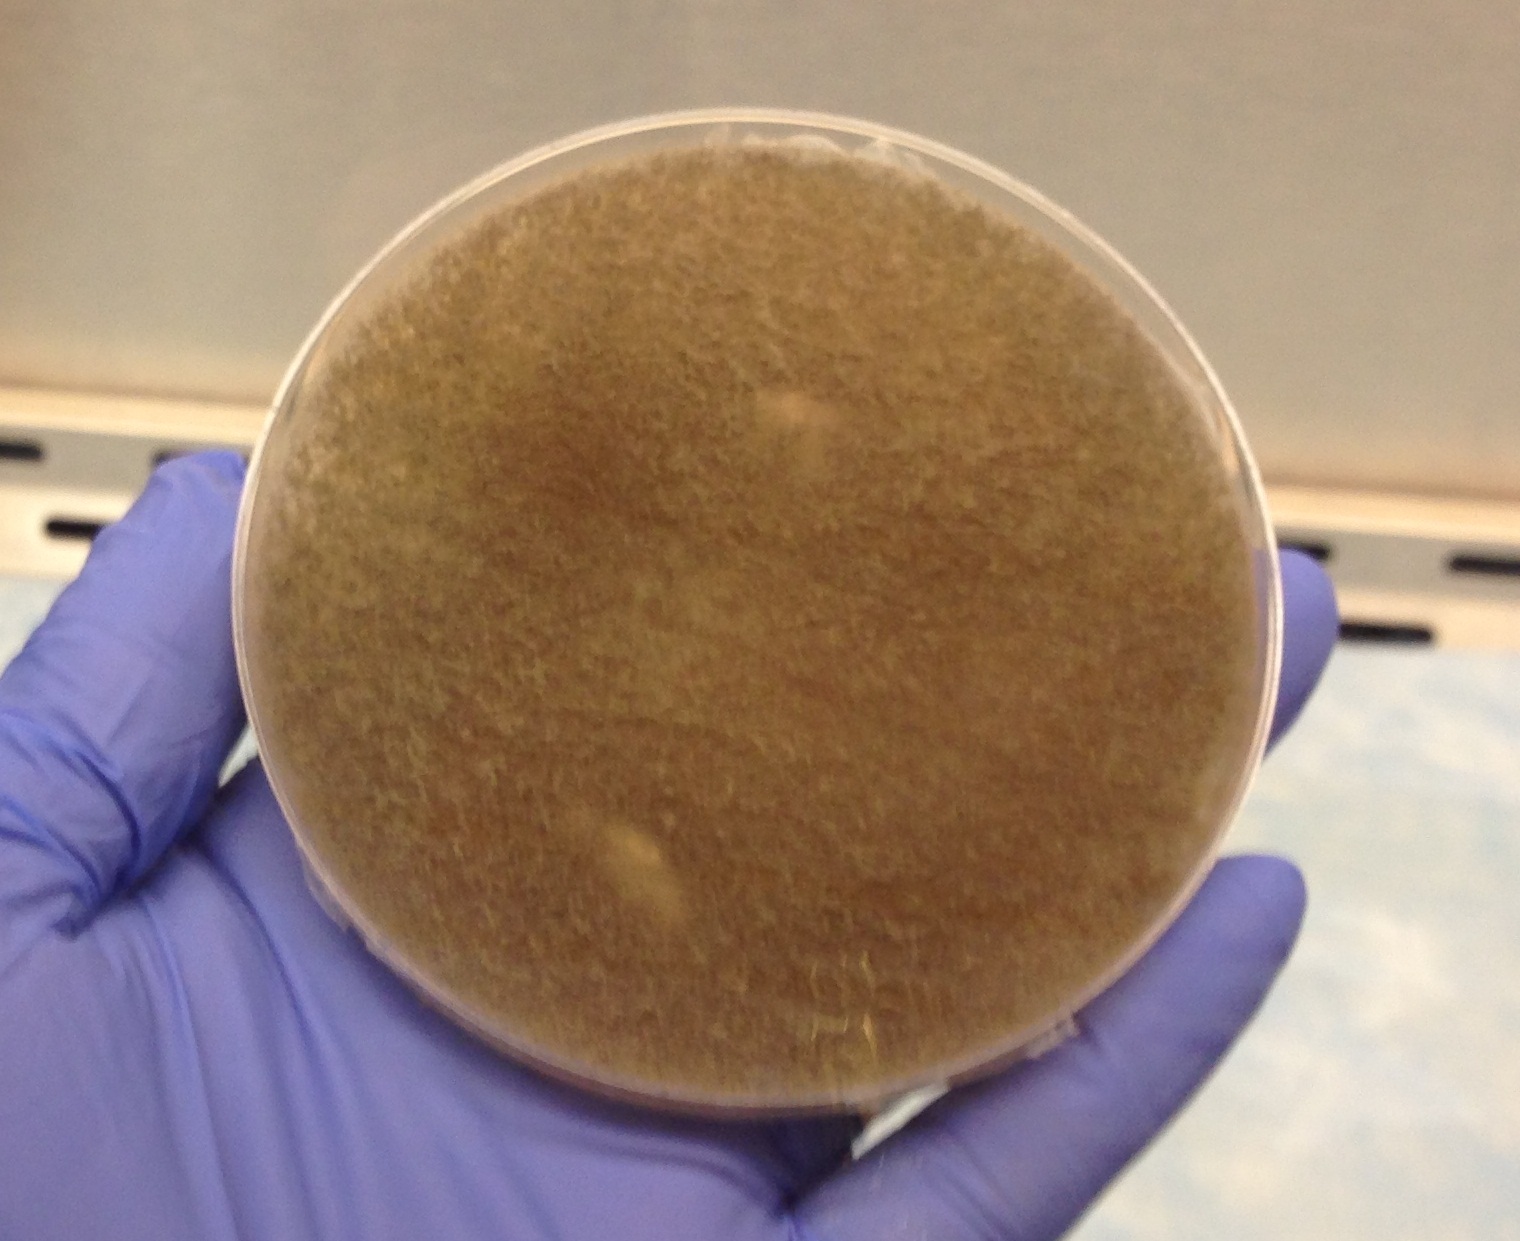

Clinical Summary:
59 year old male with a history of acute myeloid leukemia, status post allogeneic bone marrow transplant complicated by graft-versus-host disease and relapse presented to the ED complaining of flank and back pain. His work-up identified multiple pulmonary lesions, thought to be infarcts and a left upper extremity deep vein thrombosis. He was started on cefepime for neutropenic fever and lovenox for the emboli. His symptoms worsened and imaging revealed progressive lesions in the lung that were concerning for invasive aspergillosis. A biopsy of one of the lesions was non-diagnostic but an aspergillus serum antigen test was positive. He was started on voriconazole. He remained hospitalized and began showing improvement, but then again developed a febrile neutropenia and became hypotensive with a decreased hemoglobin level. A CT of the abdomen showed typhlitis in the cecum and possible liver phlegmons, and a CT of the chest showed bilateral pulmonary effusions. He went into respiratory failure and passed away. An autopsy was performed and they sent lung tissue for fungal cultures.
Microbiology:
Plates:

Temperature Studies:
The mold grew at both 37° and 42°C.
Discussion:
The above findings lead to the classification of a Zygomycete which are hyaline, pauciseptate molds that include Rhizopus, Mucor, Absidia, Rhizomucor, Synecephalastrum, Cunninghamella, and others.
The colonies are fluffy, white to gray or brown. They are rapid-growers and diffusely cover the agar within 24-96 hours. The hyphae appear to be coarse and fill the entire culture dish with loose, grayish hyphae dotted with brown or black sporangia. It is not possible to differentiate the organisms based on colony morphology. Temperature studies can differentiate between some species: Rhizopus grows best between 40-50°C; Rhizomucor grows best around 38-58°C; Mucor grows best at less than 37°C; Absidia grows between 45-50°. Since our specimen grew at both 37° and 42°C, that would lead us to have Rhizomucor high on our differential.
Zygomycetes produce large, ribbon-like hyphae that are irregular in diameter and contain occasional septae. Classification of specific organisms relies on identifying the characteristic saclike fruiting structures called sporangia. The sporangia produce sporangiospores, which are within the sporangia and are spherical and yellow or brown. Each sporangium is formed at the tip of a sporangiophore which is a supporting structure. The sporangiophores are connected by hyphae with occasional septations called stolons. These are contact points where rootlike structures called rhizoids attach to the hyphae. The presence and location of the rhizoids helps to identify the organism. Rhizopus has unbranched sporangiophores with rhizoids at their base where the stolon arises. Mucor has singularly produced or branched sporangiophores that have round sporangium filled with sporangiospores at their tips. It does not have rhizoids or stolons. Absidia has rhizoids that are between sporangiophores, and the sporangia are pyriform and have a funnel-shaped area called apophysis at the junction of the sporangium and the sporangiophore. Usually a septum is formed in the sporangiophore just below the sporangium. Our microscopic exam did not show any rhizoids at first, but a second exam after a longer growth period showed potential rhizoids at the base of the sporangiophores, which would lead us to have Rhizopus on our differential. Our case did not clearly define itself at the species level, so it was signed out as a Zygomycete and there were no treatment implications.
Zygomycetes are not a common cause of infection, but are an important cause of morbidity and mortality in patients who are immunocompromised. They have a worldwide distribution and are commonly found on decaying vegetable matter, soil, or old bread. Infection occurs by inhalation of spores, and once established, it is rapidly progressive, particularly in patients with diabetes mellitus who have infections that involve the sinuses. The organisms have a propensity for vascular invasion and rapidly produce thrombosis and necrosis of tissue. A common presentation is invasion within the nasal mucosa, palate, sinuses, orbit, face, and brain showing massive necrosis with vascular invasion and infarction. Perineural invasion can also occur which can spread retro-orbitally into the brain. They can also infect the lungs and GI tract as well as have disseminated infection. They can cause skin infections in patients who have severe burns and infections of subcutaneous tissue of patients who have undergone surgery.
Follow up:





The histology on H&E stain shows areas of necrosis with faint septate hyphae as well as broad, ribbon-like hyphae within the vasculature. The silver stain nicely highlights the broad hyphae which we can identify as a zygomycete. The silver stain also accentuated the massive amounts of thinner hyphae with parallel walls and 45 degree branching which is consistent with aspergillus. This patient was found to have both an aspergillus infection which caused the positive serum antigen test, but then also developed a zygomycete infection which led to his death. We did not identify aspergillus on our fungal culture which may be explained by several possibilities. Our patient had been treated with voriconazole for a potential aspergillus infection which may make it more difficult for the aspergillus to grow on fungal culture. Zygomycetes are rapid growers which could have inhibited the growth of another organism or could have inhibited our ability to identify a second organism growing on the plate.
Kirsten Threlkeld, MD is a 4th year anatomic and clinical pathology resident at the University of Vermont Medical Center.
-Christi Wojewoda, MD, is the Director of Clinical Microbiology at the University of Vermont Medical Center and an Assistant Professor at the University of Vermont.
